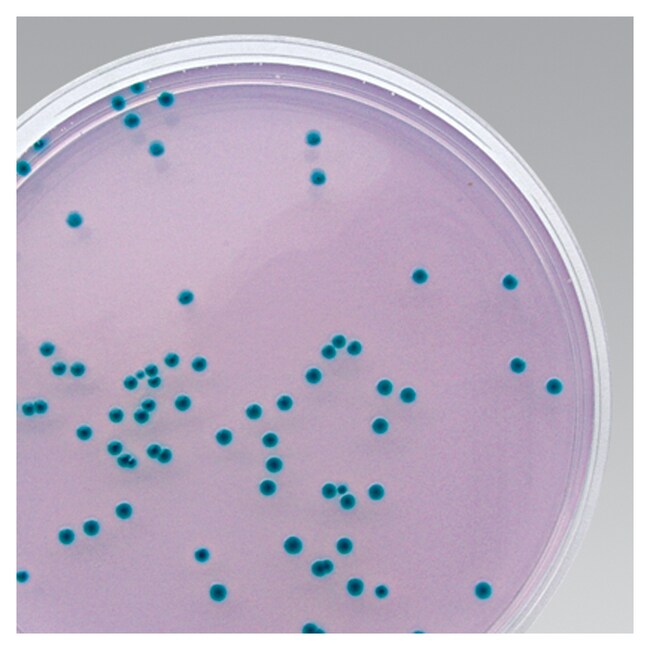
Cronobacter sakazakii Isolation Agar (ISO) (Dehydrated)

Search
Cronobacter sakazakii Isolation Agar (ISO) (Dehydrated)
Detect and enumerate Chronobacter sakazakii in milk and milk samples as described in ISO TS/22964:2017 with this medium.
| Catalog Number | Quantity |
|---|---|
| CM1134B | 500 g |
Detect and enumerate Cronobacter sakazakii in milk and milk samples as described in ISO TS/22964:2006 with Thermo Scientific™ Oxoid™ Cronobacter sakazakii Isolation Agar, when used in conjunction with Modified Lauryl Sulphate Broth (CM1133 and SR0247E). A chromogenic substrate present in the medium detects the α-glucosidase enzyme produced by Cronobacter sakazakii. Hydrolysis of the substrate results in blue-green colonies on this medium.
Cronobacter sakazakii is a Gram-negative rod-shaped bacterium that rarely causes disease in healthy adults. It has been implicated in outbreaks of disease in premature infants (neonates). Research suggests that neonates, or those infants who have other medical conditions, are more susceptible to this infection. Most reported cases of infection are severe, including sepsis (bacteria in the blood), meningitis, or necrotizing enterocolitis (severe intestinal infection).
Use Cronobacter sakazakii Isolation Agar for differentiation and enumeration of Cronobacter sakazakii from infant formula and other food samples.
- Selective: Due to the presence of sodium desoxycholate and crystal violet the medium is selective against most Gram-positive organisms.
- Easy-to-read: Cronobacter sakazakii produces blue-green colonies on this medium.
Cronobacter spp. have been isolated at low levels from powdered infant formulae, and the organisms’ high tolerance to desiccation provides a competitive advantage in the dry environments of milk powder factories, increasing the risk of product contamination1.
In response to concerns over this pathogen, a collaborative technical specification for the detection of Cronobacter in milk and milk products was jointly issued by ISO and IDF, as ISO/TS 22964:20062. This recommended pre-enrichment in BPW, selective enrichment in mLST/vancomycin broth and plating on Enterobacter sakazakii Isolation Agar. Positive colonies are confirmed on the basis of sugar utilisation, decarboxylase activity, as well as yellow pigmentation. The technical specification has since been superseded and among other changes the isolation medium has been replaced with Chromogenic Cronobacter Isolation Agar (CCI)3.
Not all products are available for sale in all territories. Please inquire.
Remel™ and Oxoid™ products are now part of the Thermo Scientific brand
General References:
- Lai, K.K. (2001) Enterobacter sakazakii Infections among Neonates, Infants, Children, and Adults. Case Reports and a Review of the Literature. Medicine, 80, 113-122.
- Anonymous. 2006. Milk and milk products-detection of Enterobacter sakazakii Technical specification ISO/TS 22964:2006
- ISO International Standardisation Organisation. Microbiology of the food chain -Horizontal method for the detection of Cronobacter spp. ISO 22964:2017.